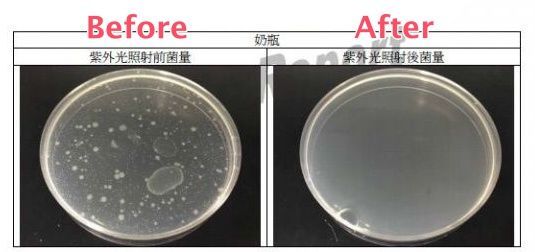
Minerva 米諾娃 六分鐘奶瓶殺菌器

---- 限時優惠已結束 ----
寶寶的奶瓶在家可以用蒸氣、紫外線消毒鍋,但在外頭尤其是出遊的時候就很苦惱啦 ಥ_ಥ很多媽咪都會隨身攜帶【Minerva 米諾娃 六分鐘奶瓶殺菌器】放在包包裡,只要六分鐘就可以達到 99.9% 消毒,這樣出門在外也不怕囉!

尺寸:8.7 x 8.7 x 29 cm
材質:抗 UV PP
重量:285g
使用 A3 鹼性電池 2 顆(約可消毒10-12次)時間約6分鐘,可使用充電電池
奶嘴、咬咬玩具通通是寶寶成長過程中的好夥伴!要保證完全不落地、不接觸髒污真的太難?特別是外出遊玩,總不能把家裡重重的ㄍㄟ西全部搬出門吧?

【Minerva 米諾娃 六分鐘奶瓶殺菌器】和一般家用的消毒鍋放在一起比比看!體積是不是真的很小呢?如此一來出門只要直接丟包包或行李箱裡就可以了~而且重量很輕只有 285 克唷!

使用方法也很簡單喔!媽咪趕快跟著我們一起開箱吧(*´∀`)~♥
第一個步驟當然就是裝上電池啦~使用 A3 電池兩顆,對準正負極安裝即可!建議媽咪使用鹼性電池或是充電電池,每次使用六分鐘約可使用 10-12 次唷~

瓶身前後都會有個方塊,媽咪只要單手往內壓,再用另一隻手將蓋子往上拉就可以開啟囉~
![]()
蓋子的頂部就是紫外線殺菌燈管,也會同時釋出臭氧達到 99.9% 的殺菌效果喔~

只要將洗淨後的奶瓶拆解,放入殺菌器再蓋上上蓋就可以啦~(寬口徑、一般口徑奶瓶皆適用)
(奶瓶清洗過後甩乾即可放入六分鐘殺菌器內消毒,若不喜歡奶瓶濕濕的可以先擦乾再行消毒)

不僅是奶瓶,只是可以放入殺菌器容器內的東西都可以一併做殺菌


蓋上上蓋之後,按下頂部按鈕看到燈管發亮,靜待六分鐘過後就可以得到一個乾淨的奶瓶啦~是不是真的超方便也超簡單哩!

Minerva 米諾娃六分鐘奶瓶殺菌器享有一年保固!趕緊購入外出再也不用煩惱啦。:.゚ヽ(*´∀`)ノ゚.:。

經過全國公證測試報告,證實可在六分鐘內達到 99.9%的殺菌效力!

看看照射前後的細菌量,是不是差很多呢?
注意事項:

☁貼心小叮嚀
本團商品若拆封開箱就無法受理退換貨囉~若是正常使用且無經任何碰撞、毀損等人為因素之新品瑕疵,請在 7 日鑑賞期內(依物流紀錄之簽收日起算)反應退換貨,謝謝媽咪的包容唷!